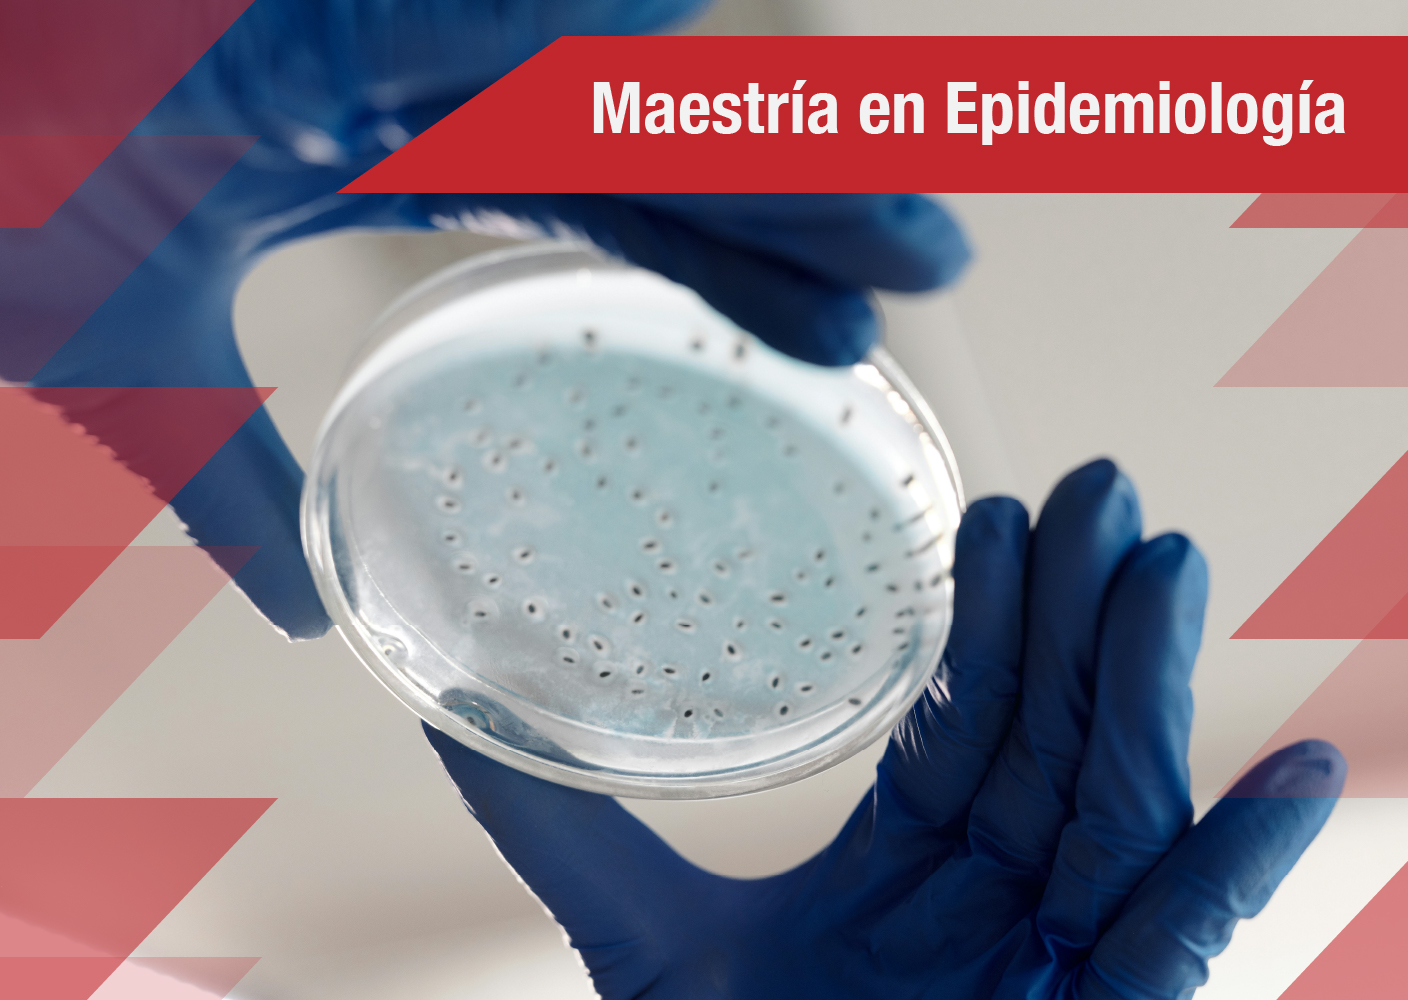

Escuela de Salud Pública
Acreditación

¿Qué es la Acreditación en Alta Calidad?
La acreditación es el acto por el cual el Estado adopta y hace público el reconocimiento que los pares académicos hacen de la comprobación que efectúa una institución sobre la calidad de sus programas académicos, su organización y funcionamiento y el cumplimiento de su función social. (Acuerdo CESU 01 de 2020)
¿Qué se evalúa?
En el proceso de autoevaluación de programas académicos se evalúan los avances, retos y aspectos a mejorar de los procesos académicos, administrativos, logísticos y de proyección con la comunidad.
- La calidad educativa y su aseguramiento
- La eficiencia y eficacia del funcionamiento interno
- El cumplimiento de los propósitos educativos y funciones misionales
- El desarrollo de las funciones sustantivas
- La consolidación de proyectos de investigación, innovación, desarrollo tecnológico o de creación
- Los procesos de generación de conocimiento, desarrollo tecnológico e innovación
¿Cómo se evalúa?
- Mediante la reflexión interna de la institución
- Con la participación activa de todos los actores de la comunidad académica
- Recopilando información documental, descriptiva y de opinión
- Contrastando los objetivos específicos con la evidencia del desempeño
- Describiendo y reuniendo la evidencia sobre el desempeño
- Definir con claridad los criterios evaluativos
- Establecer cuáles serán los objetivos específicos que se exigen cumplir
La autoevaluación es un requisito de calidad para el otorgamiento o la renovación de los registros calificados de los programas académicos.

Fuente: Guía 03 - Autoevaluación de programas académicos e instituciones de educación superior del CNA.
Actores de los grupos de interés
Son miembros tanto de la comunidad académica como del sector externo, son responsables y protagonistas en la evaluación, identificando fortalezas y debilidades. Su participación, definida por criterios específicos, fortalece el sentido de pertenencia y el compromiso, impulsando el desarrollo y mejora del programa y la institución.

Posgrados de la Escuela de Salud Pública con Acreditación en Alta Calidad Académica

 |
 |
|
Acreditación otorgada durante 2018-2024 (en proceso de renovación) |
Acreditación otorgada durante 2021-2025 (en proceso de renovación) |
|
|
|
|
Acreditación otorgada durante 2019-2025 (en proceso de renovación) |
Acreditación otorgada durante 2019-2025 (en proceso de renovación) |
La Escuela de Salud Pública, en busca de la Renovación de Acreditación en Alta Calidad
De acuerdo con las políticas emprendidas por la Universidad del Valle dirigidas a construir una cultura de calidad y mejoramiento continuo, en la Escuela de Salud Pública, durante el año 2022, hemos iniciado nuestro proceso de Autoevaluación con fines de Renovación de Acreditación en Alta calidad para de los programas de Maestría que ofrecemos.
Para la Escuela este proceso constituye una oportunidad para reafirmar nuestro compromiso con la calidad de nuestros programas académicos, por medio de seguimiento y evaluación permanente. Por lo tanto, este es un proceso de construcción colectiva en la que todos los estamentos deben participar.

¿Qué es la Renovación de acreditación en Alta Calidad?
Este proceso se enfoca en el estudio, análisis y evaluación de la consolidación y proyección de las fortalezas que han caracterizado el programa académico. Para lo cual se tendrá en cuenta la comprobación de la efectividad de los planes de mejoramiento que integran las oportunidades de mejora identificadas a lo largo del trámite de acreditación y la capacidad innovadora que demuestre el programa académico.
Etapas del proceso de renovación de acreditación

¡La Acreditación de Alta Calidad es un compromiso de todos: Tú haces parte de éste proceso!
Grupo de Acreditación y Calidad
Dirección de Posgrados Escuela de Salud Pública
Edificio 118- Campus San Fernando 3° piso - Oficina 309
Esta dirección de correo electrónico está siendo protegida contra los robots de spam. Necesita tener JavaScript habilitado para poder verlo.
- Detalles
- Última actualización: 18 Marzo 2025
- Visto: 7108